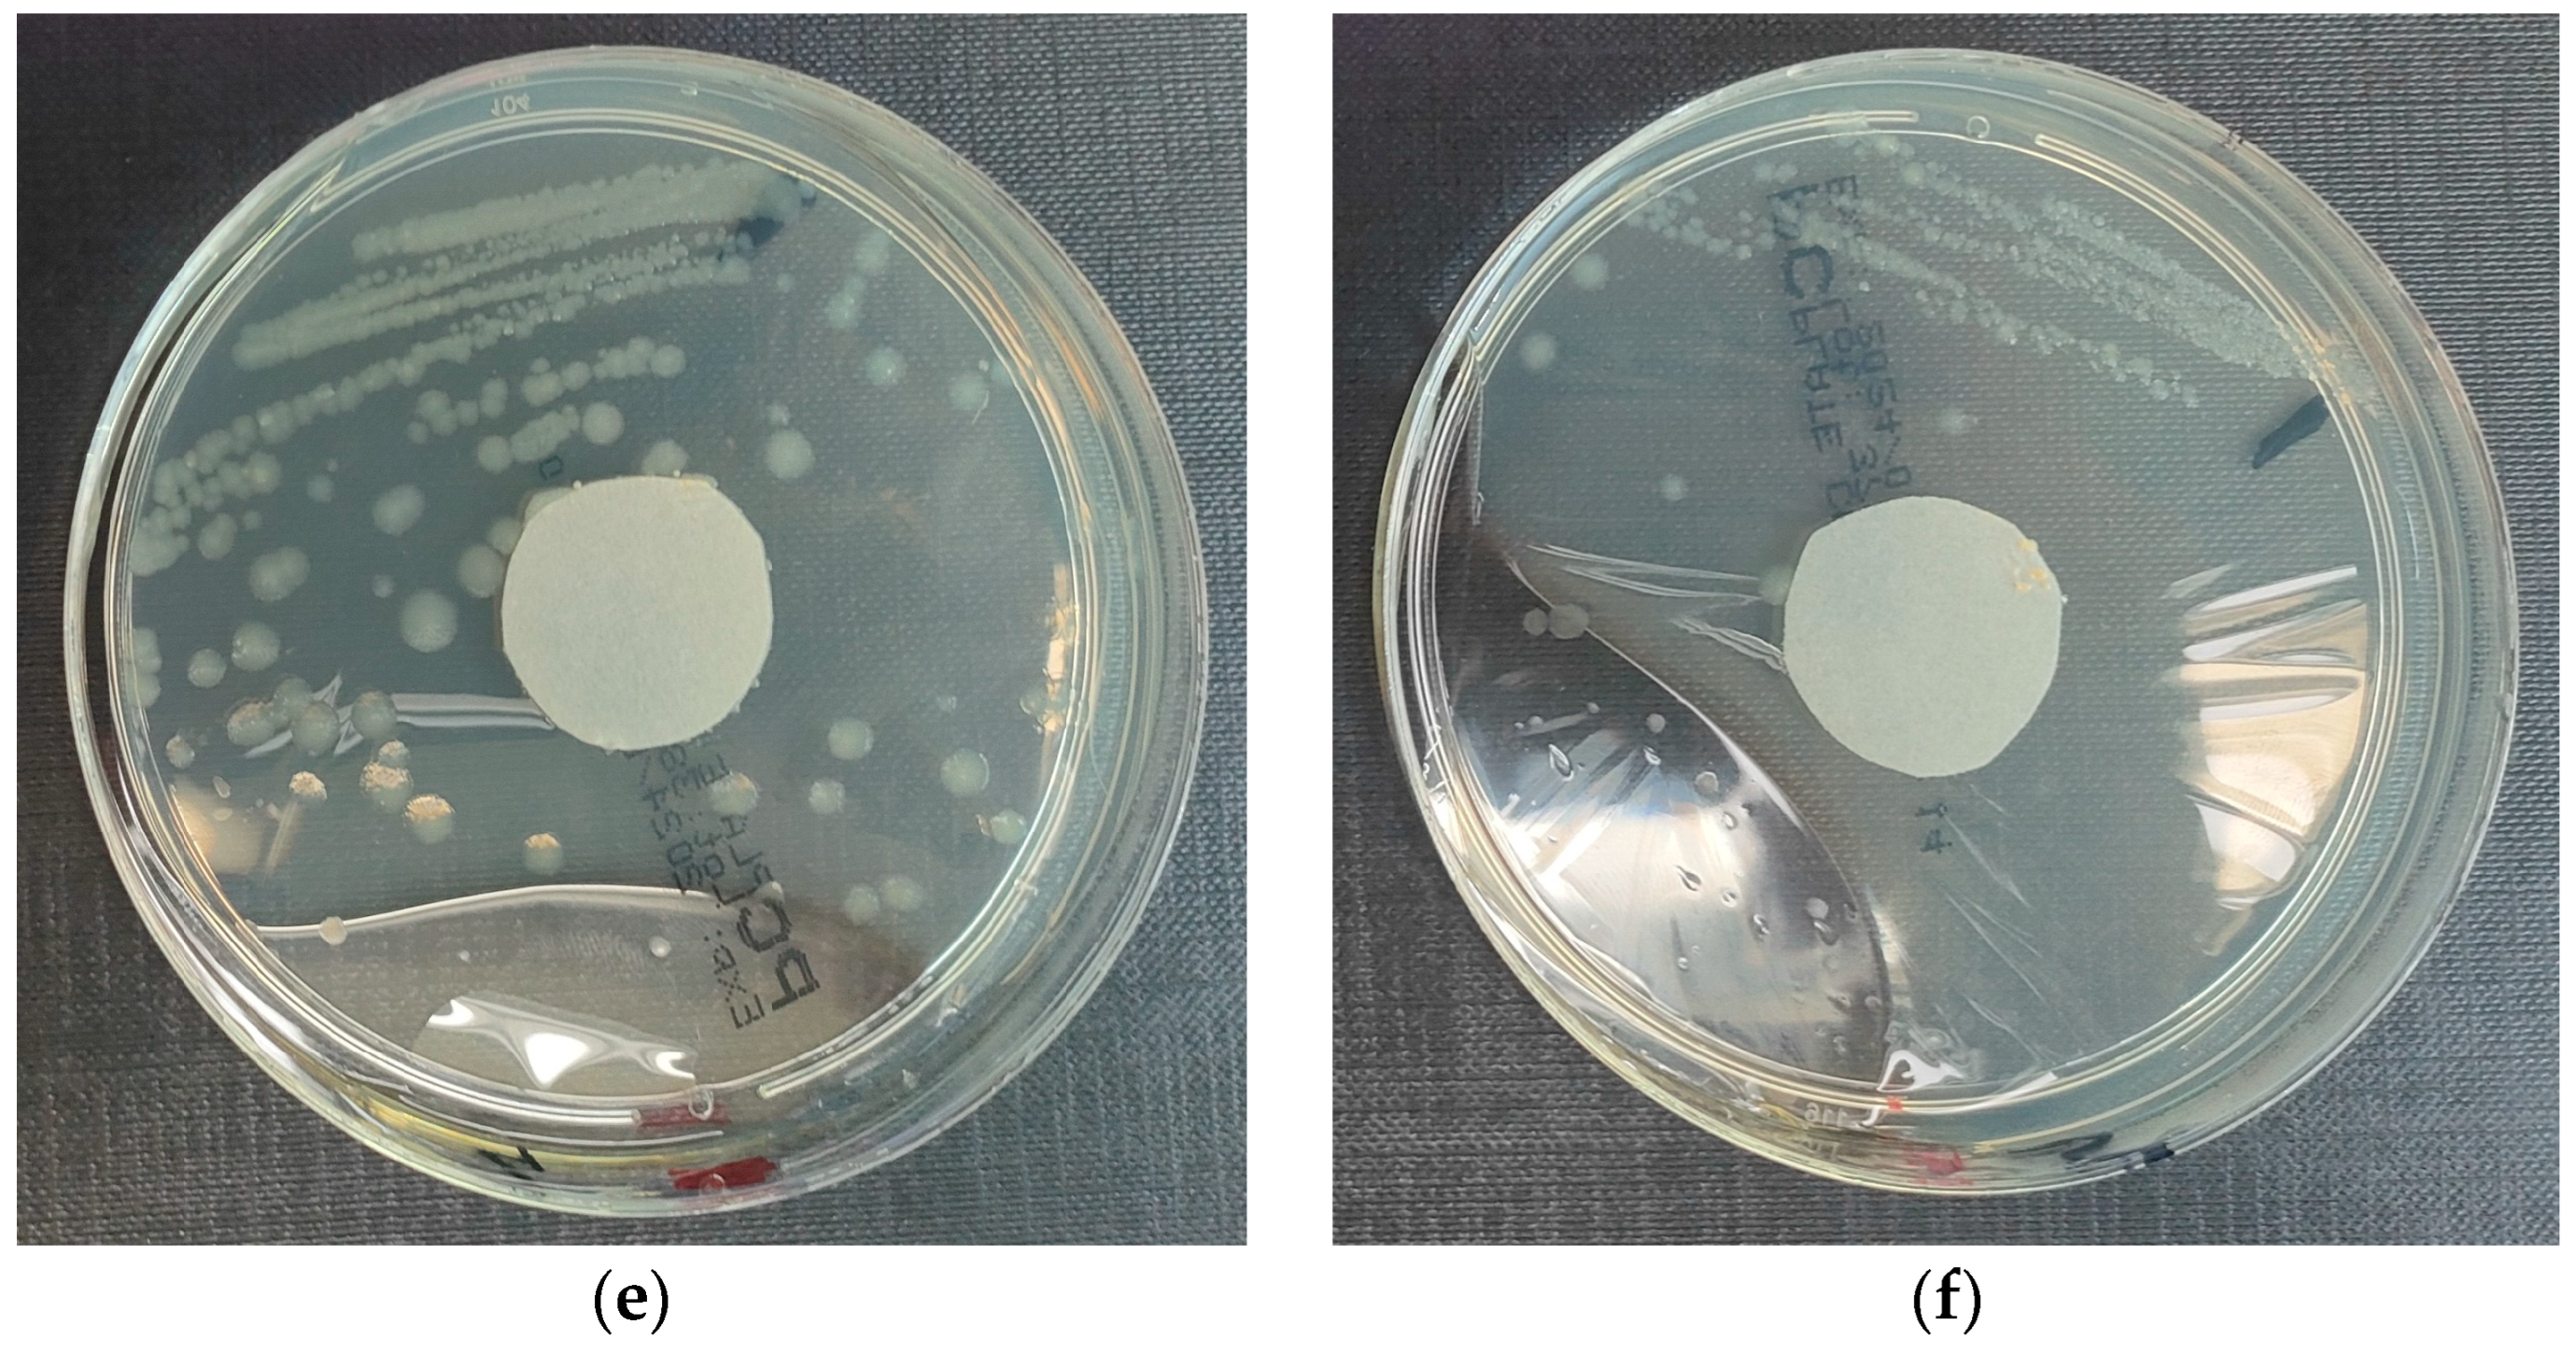
Materials 18 02560 g004b
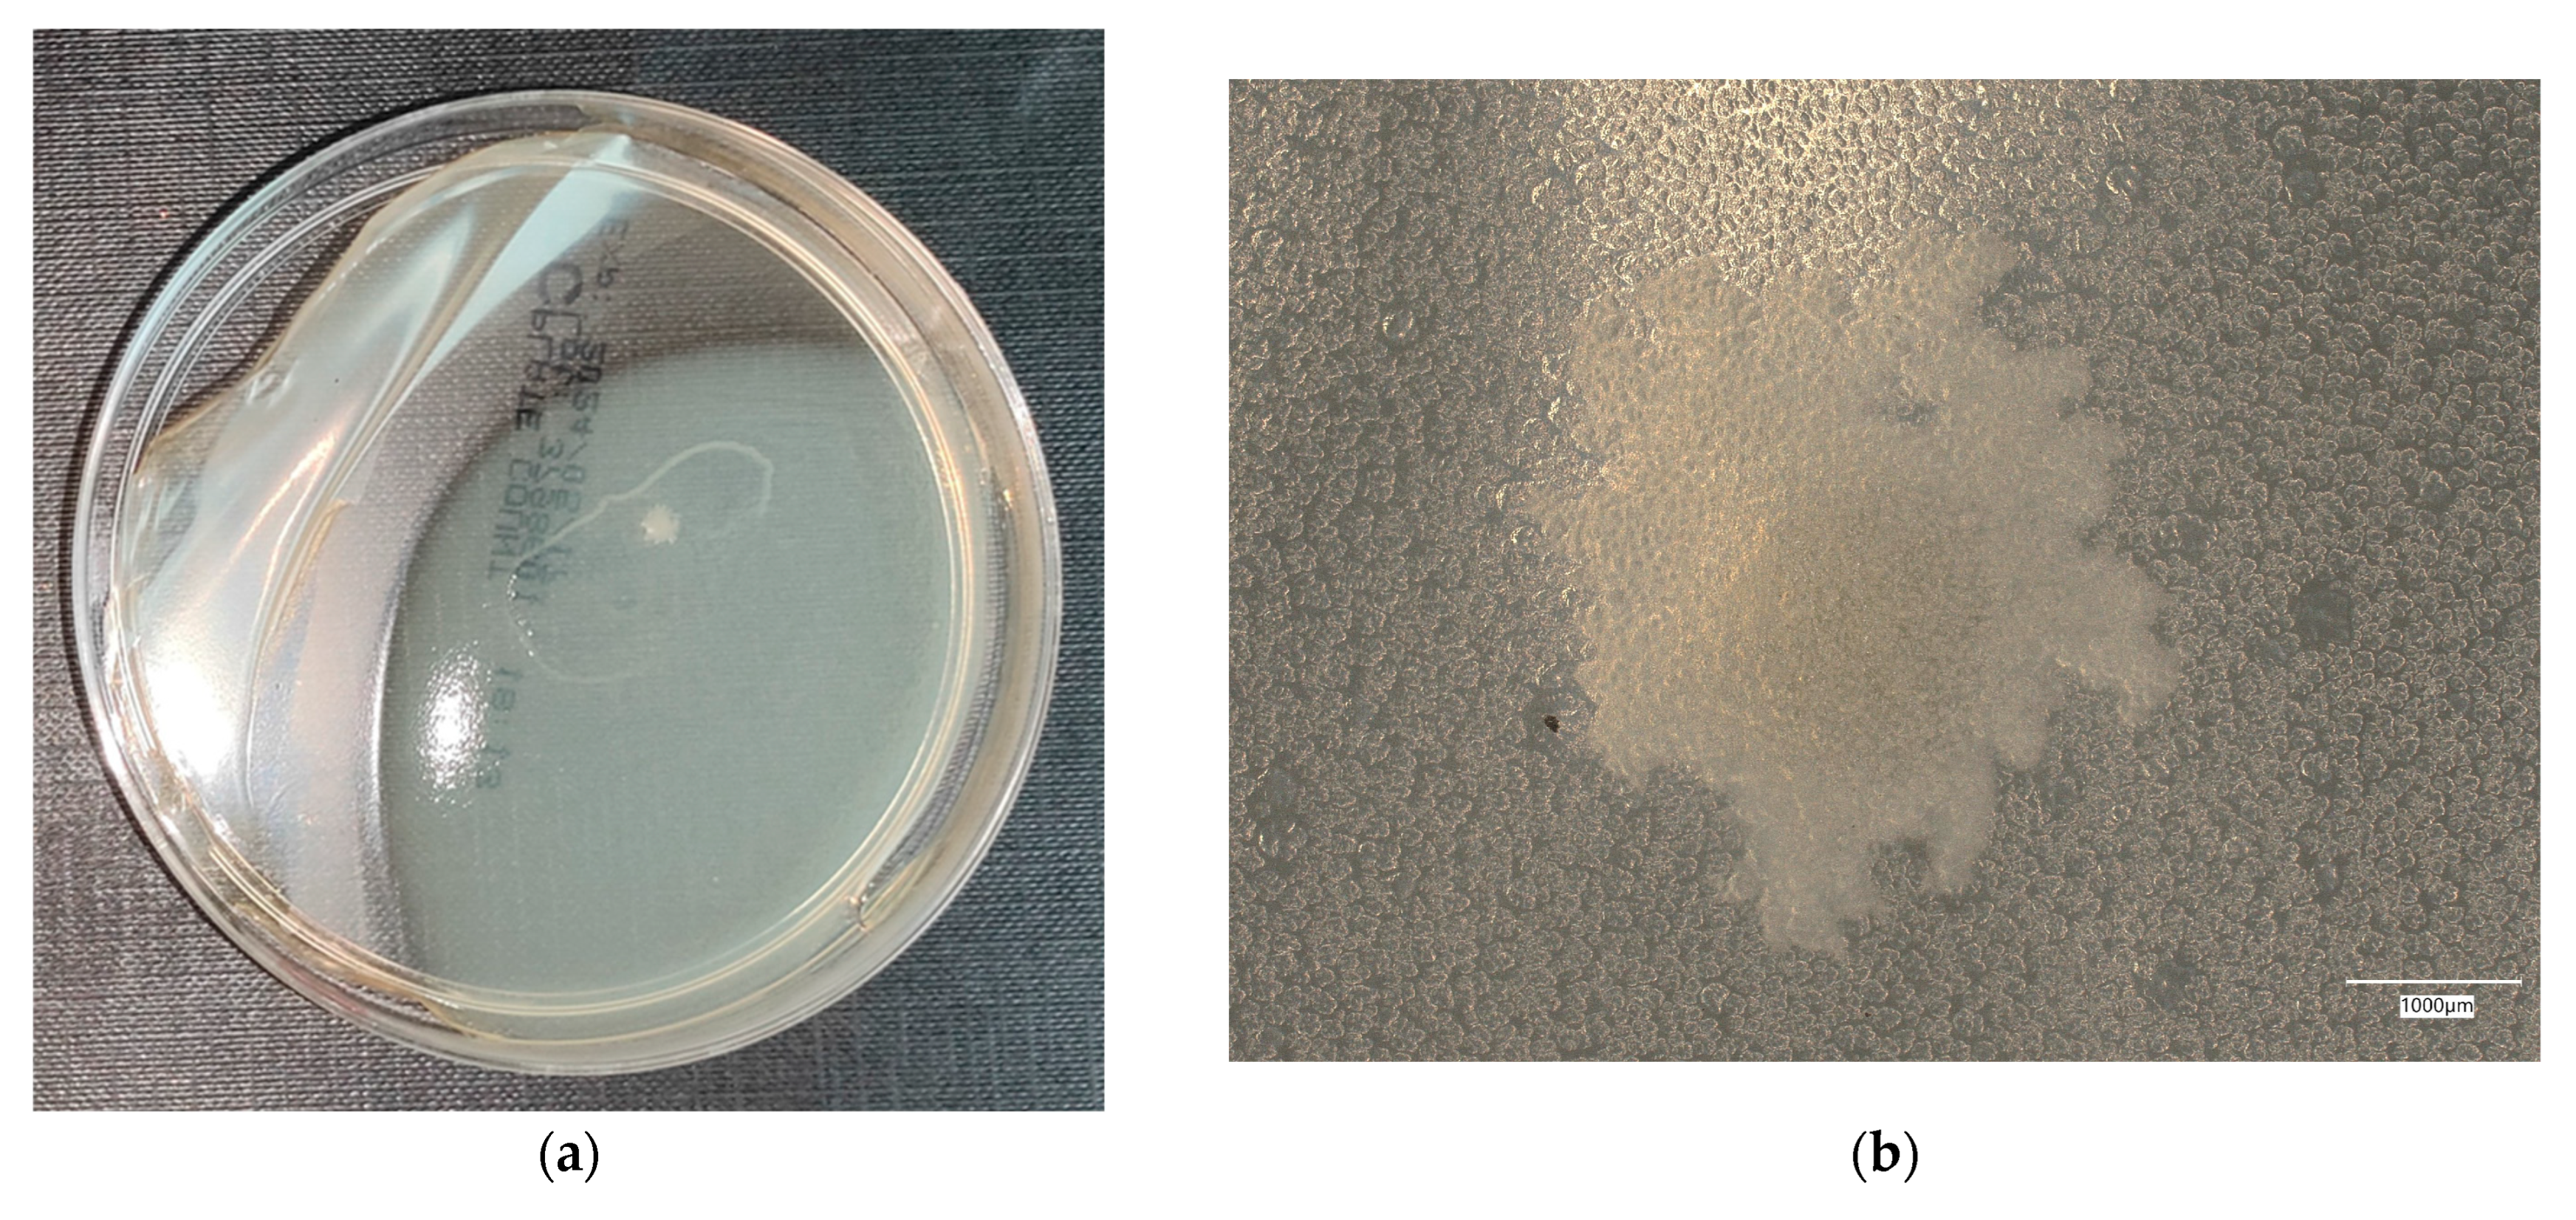
Materials 18 02560 g008a
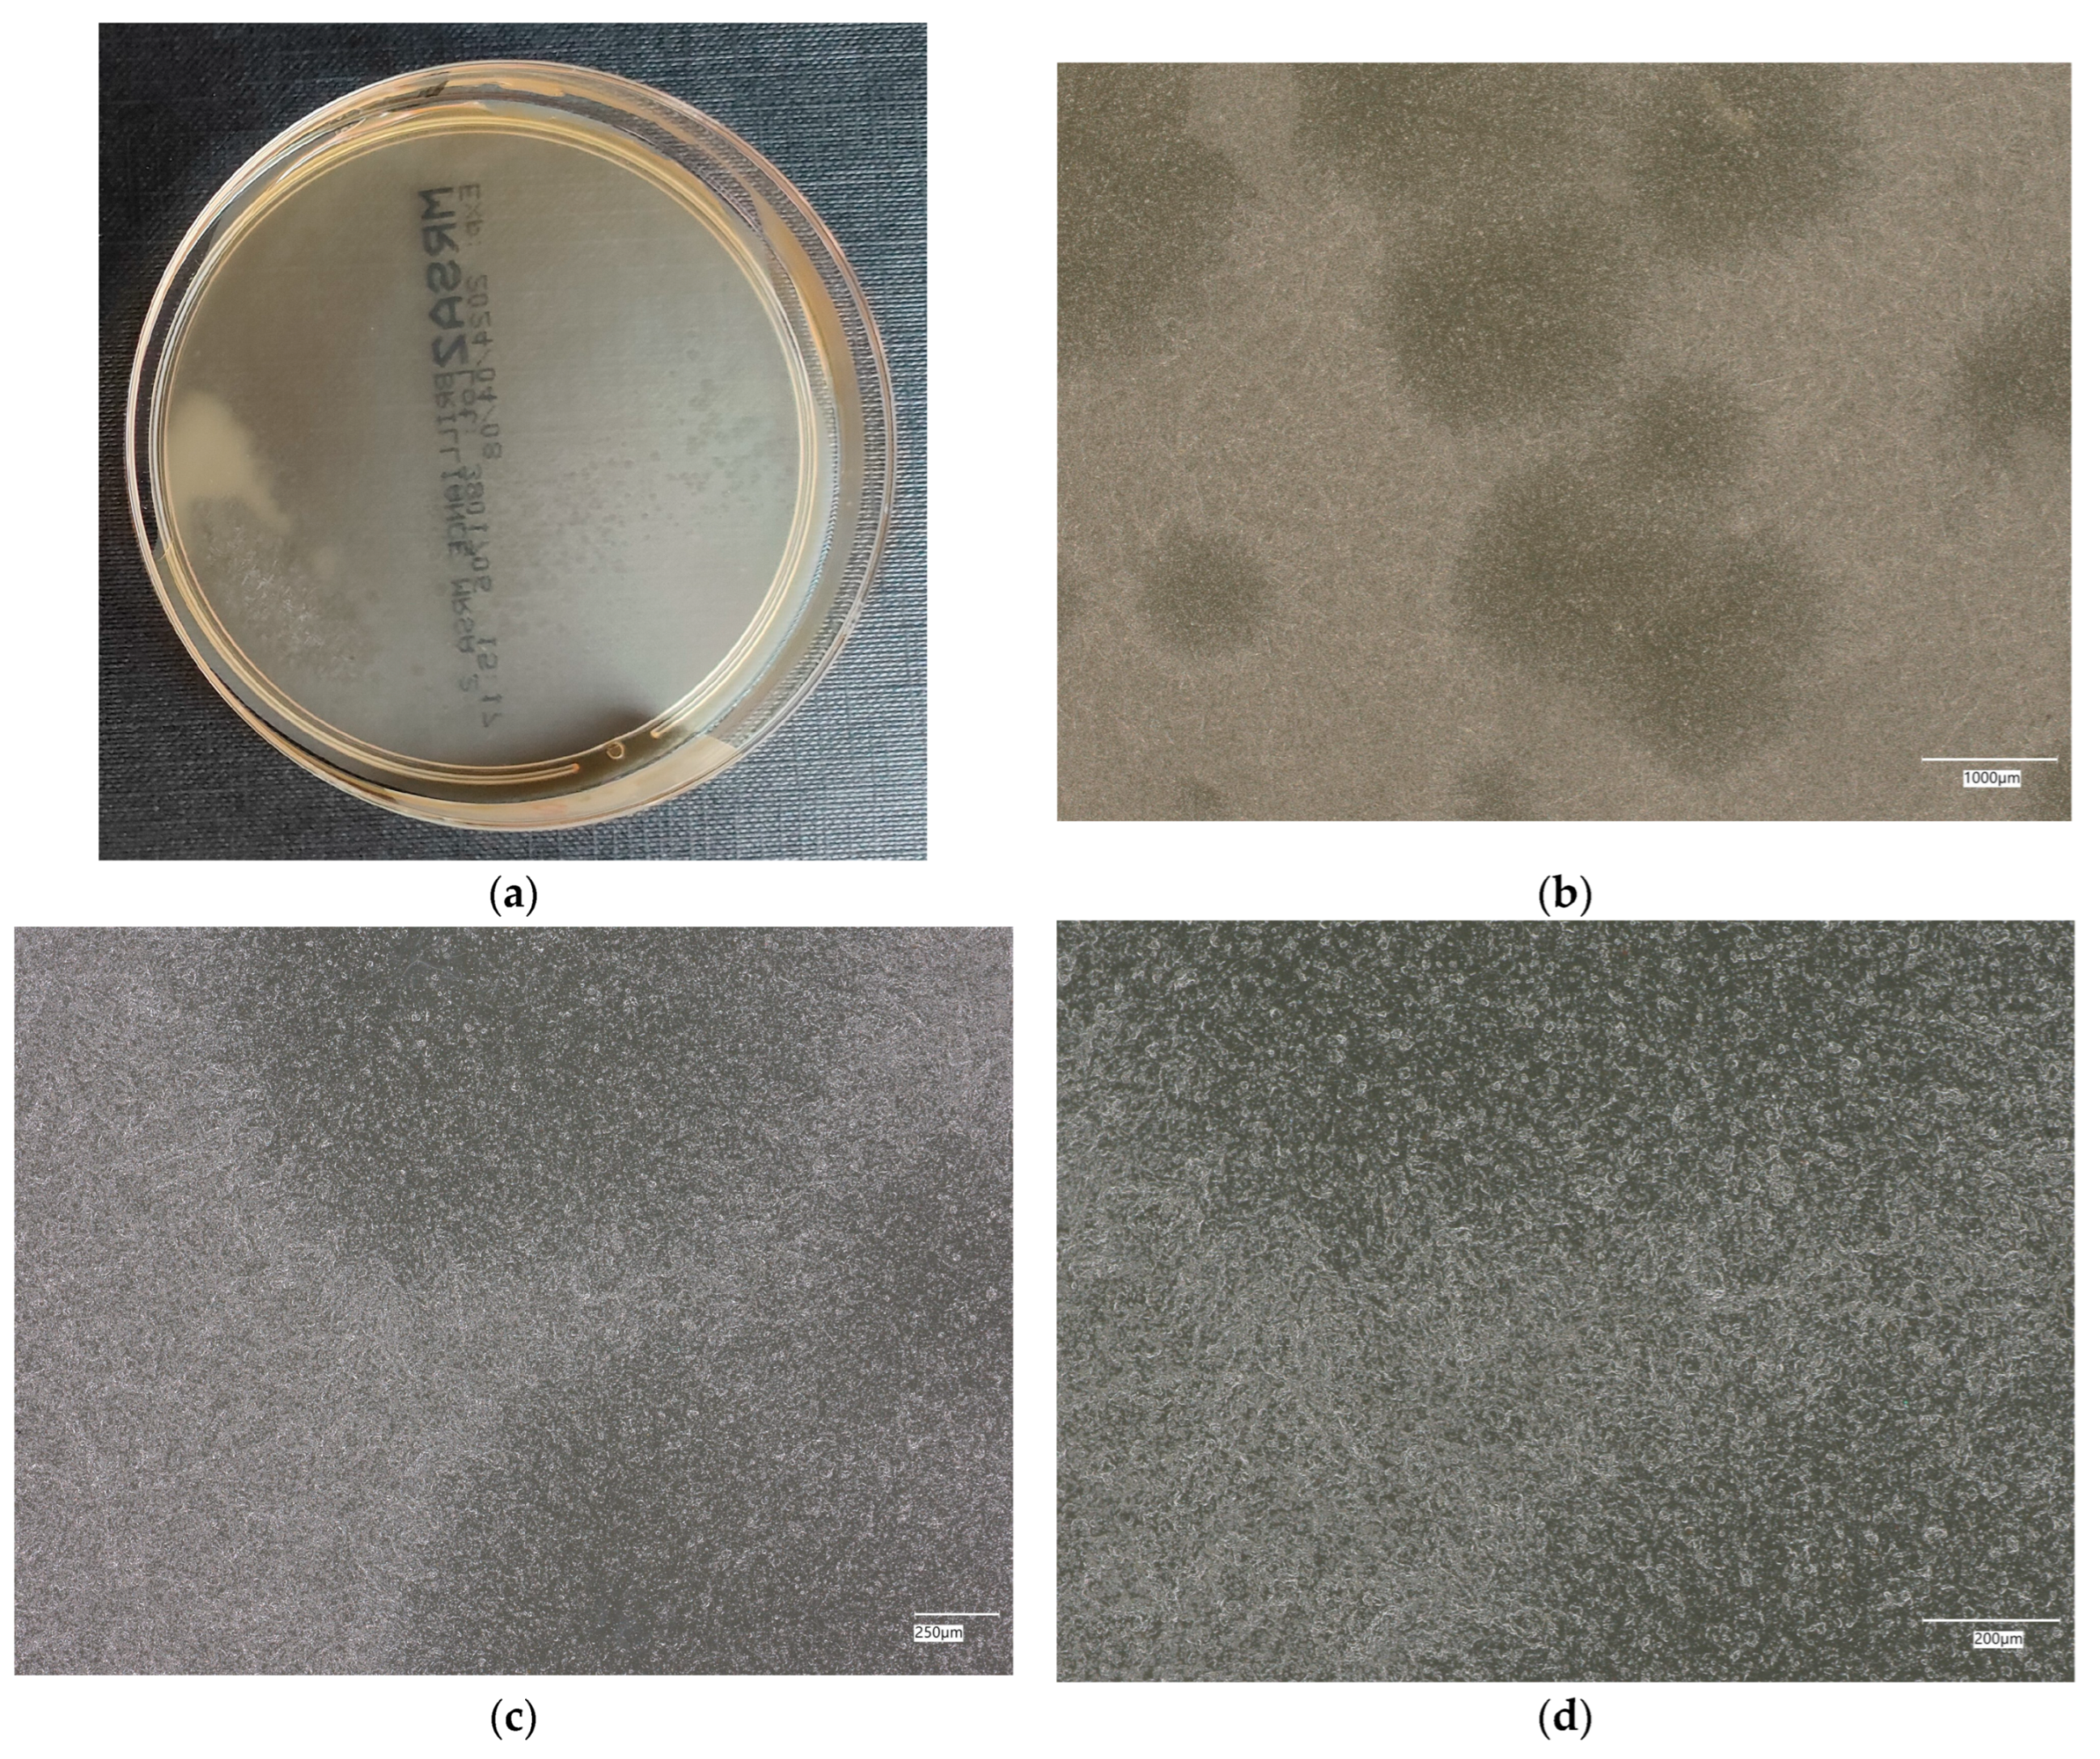
Materials 18 02560 g013
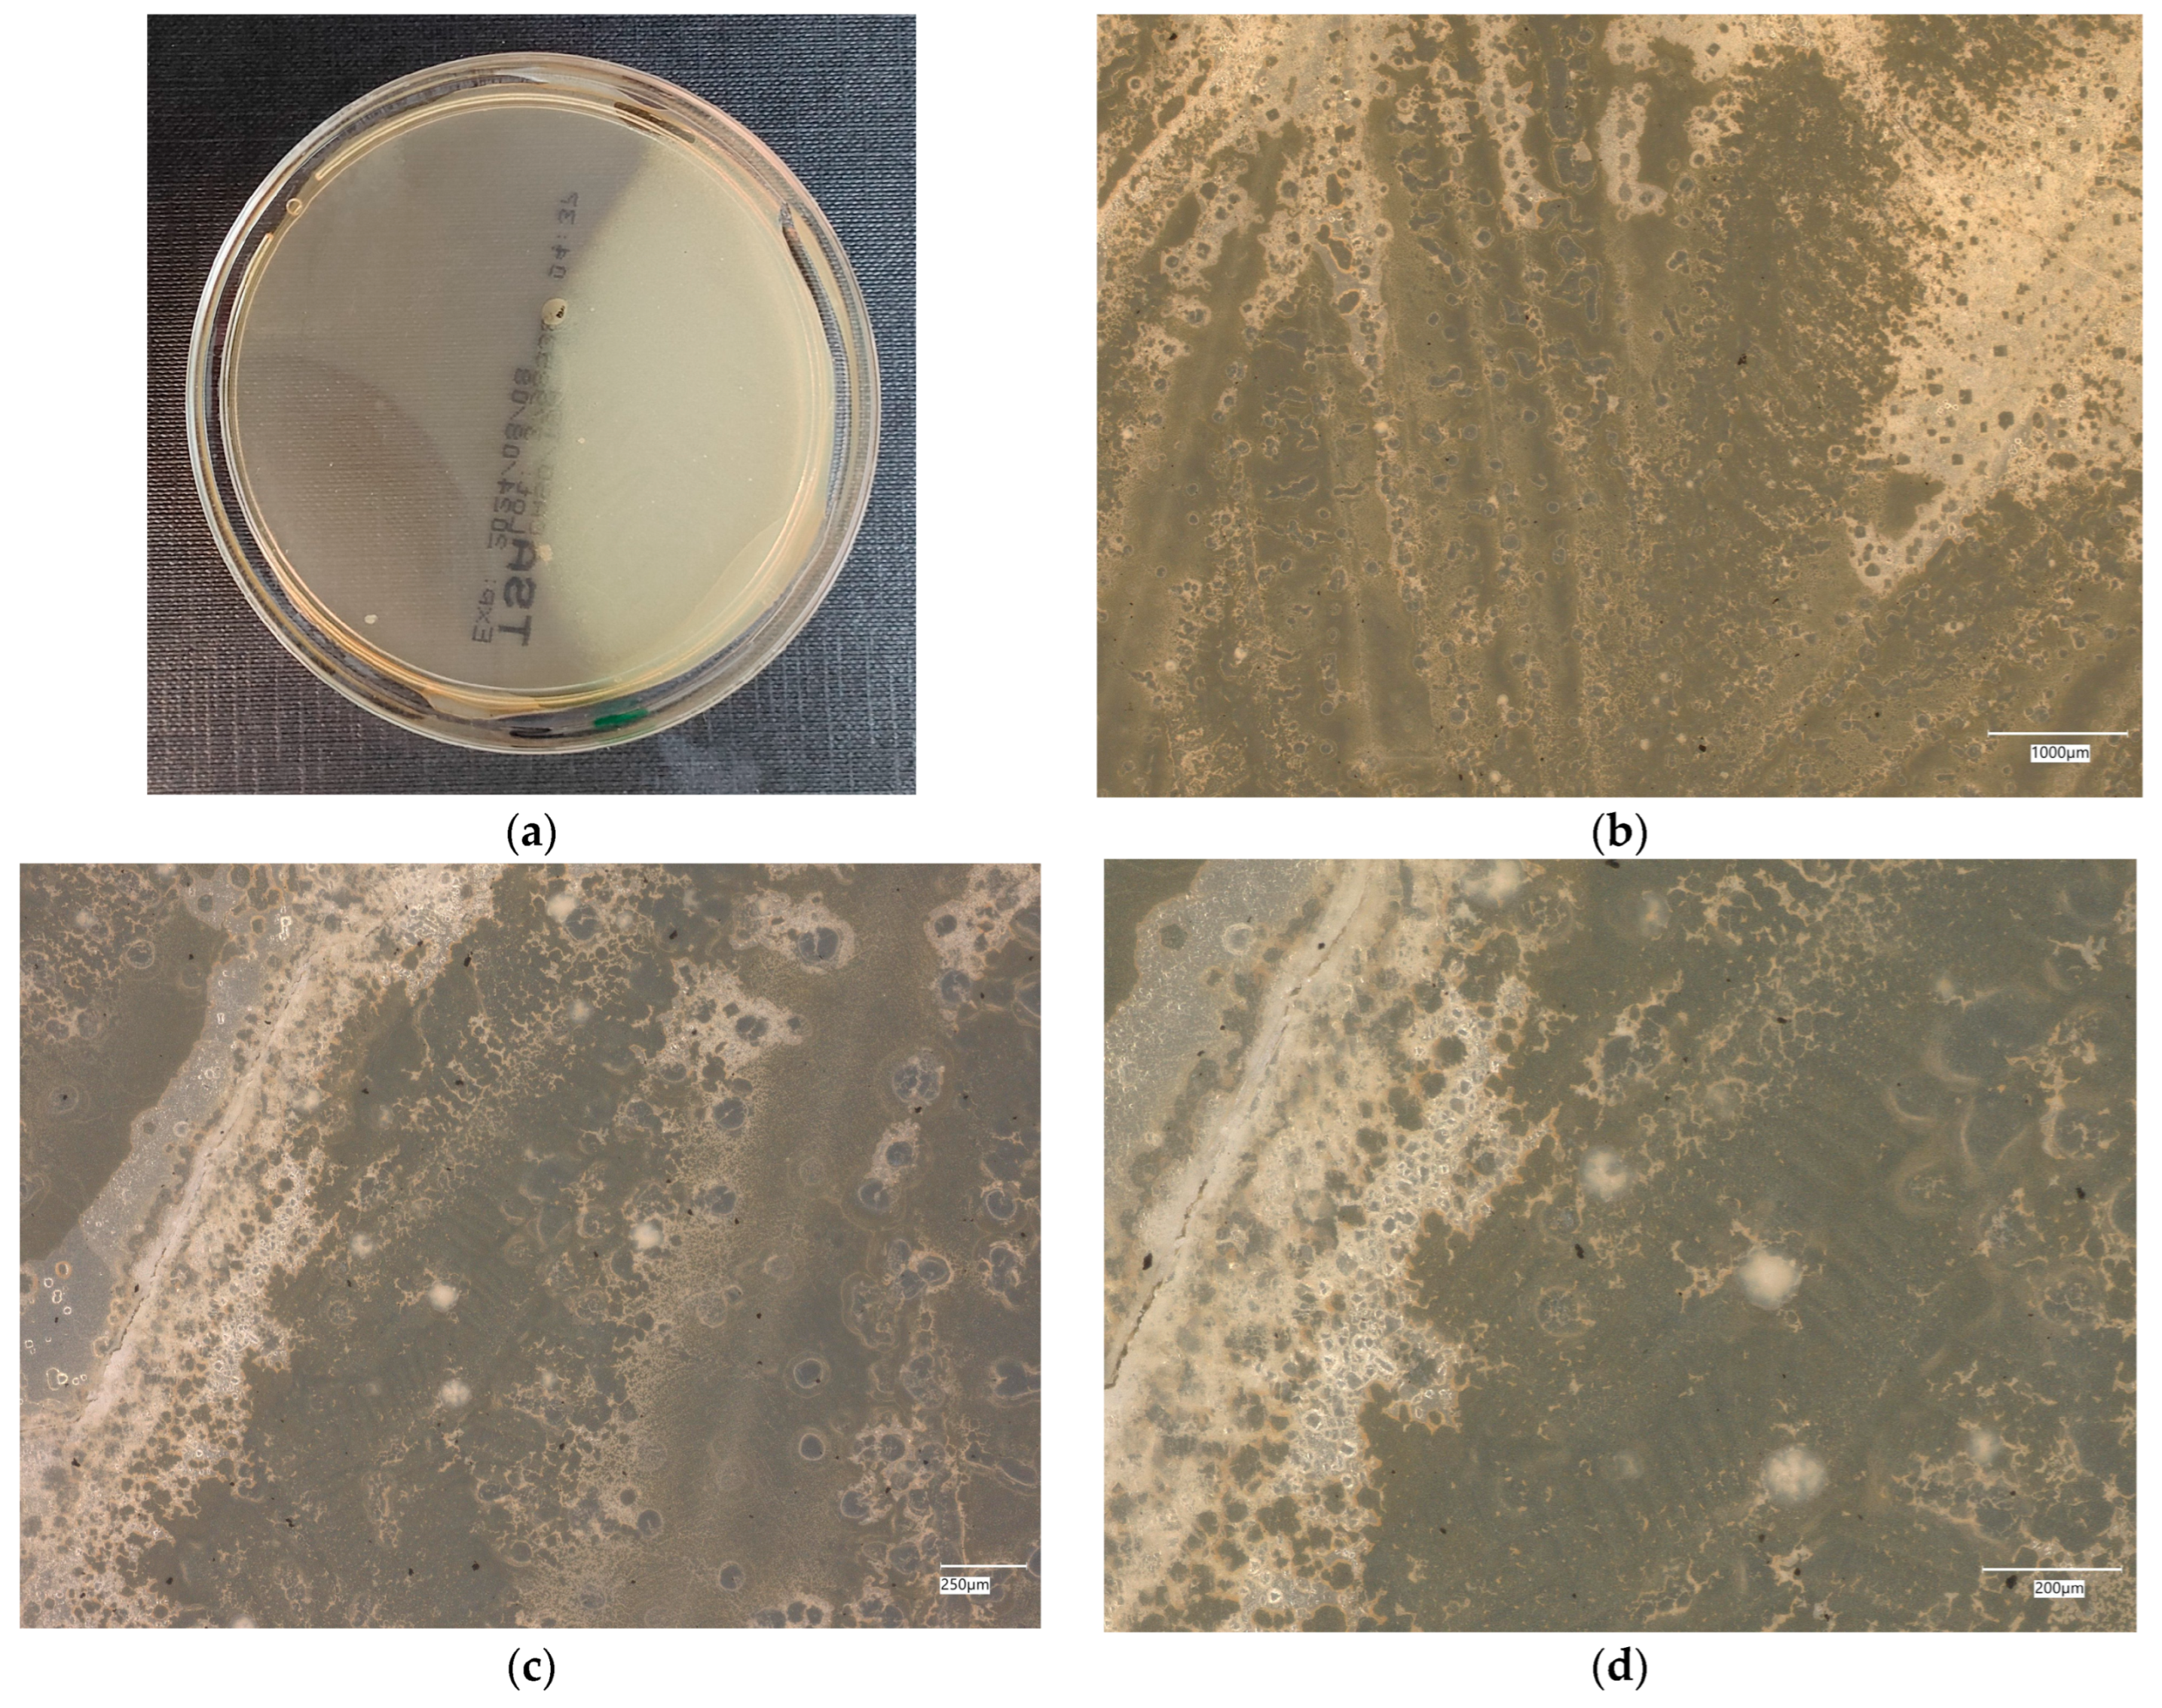
Materials 18 02560 g020

Studying the Impact of Cement-Based and Geopolymer Concrete on the Proliferation of Escherichia coli and Staphylococcus aureus in Water-Related Applications
Abstract
1. Introduction
2. Materials and Methods
2.1. Sample Preparation and Material Testing
- Fly ash—main product for geopolymerization, an industrial by-product.
- Mine tailing (coal shale) was implemented to enhance the environment-friendly character of the composite. It is a waste from mining production and can be considered as an alternative material for fly ash.
- Carbon fiber improves the flexural strength and some works also suggest the antimicrobial properties of this material [31].
- Nanosilica—improving the compressive strength, possibly increasing the coherence of the material structure and its resistance to water penetration.
- Antibacterial agent—enhancement of antibacterial properties.
- Fly ash—the amount was dependent on the amount of other ingredients, complementing 100%.
- Mine tailing (coal shale)—the amount is based on previous research, taking into consideration the mechanical properties of the materials [32].
- Carbon fiber—the amount was determined by the workability of the mixture and the ratio between price and enhanced mechanical properties. The amount is based on the previous investigation [33].
- Nanosilica—the amount based on the literature investigation [34].
- Antibacterial agent—the amount was experimentally added as 0.5 and 1% by mass. These percentages were the results of a literature investigation [34].
2.2. Bacteria Cultivation and Assessment of Anti-Bacterial Properties
- Fifteen material discs of five variants;
- Two sets Escherichia coli (Gram-negative bacteria);
- Two sets Staphylococcus aureus (Gram-positive bacteria);
- An agar microbiological medium is used to count many varieties of living organisms;
- Soy agar medium is used as a reference medium for the cultivation of a wide range of microorganisms;
- Chromogenic plates for selective isolation and direct identification of S. aureus bacteria;
- Chromogenic plates for the detection of E. coli bacteria after incubation;
- 0.9% NaCl solution;
- Tissue paper discs with a diameter of 1 cm, treated with a UV sterilizer.
3. Results
3.1. Geopolymer Investigations
3.2. pH Measurement
3.3. Assessment of Microorganism Growth Inhibition by Cement and Geopolymer
3.3.1. Escherichia coli Microorganism
- Results after incubation at 28–32 °C for 69–75 h.
- Positive controls’ inoculum of 50–120 colony-forming units:
- ○
- Bacillus subtilis ATCC® 6633 (WDCM 00003)—irregular straw colonies.
- ○
- E. coli ATCC® 25922 (WDCM 00013)—straw colonies.
- ○
- E. coli ATCC® 8739 (WDCM 00012)—straw colonies.
- ○
- S. aureus ATCC® 25923 (WDCM 00034)—cream/straw colonies.
- Colony counts shall be equal to or greater than 70% of the control medium (Tryptone Soya Agar).
3.3.2. Staphylococcus aureus Microorganism
- Results after incubation at 28–32 °C for 69–75 h.
- Positive controls of inoculum of 50–120 colony-forming units:
- ○
- Bacillus subtilis ATCC® 6633 (WDCM 00003)—irregular straw colonies.
- ○
- E. coli ATCC® 25922 (WDCM 00013)—straw colonies.
- ○
- E. coli ATCC® 8739 (WDCM 00012)—straw colonies.
- ○
- S. aureus ATCC® 25923 (WDCM 00034)—cream/straw colonies.
- Colony counts shall be equal to or greater than 70% of the control medium (Tryptone Soya Agar).
3.4. Evaluation of Microbial Multiplication in Liquid with Cement and Geopolymer Samples
3.4.1. Escherichia coli on Reference Plates
- Results after incubation at 28–32 °C for 69–75 h.
- Positive controls of inoculum of 50–120 colony-forming units:
- ○
- Bacillus subtilis ATCC® 6633 (WDCM 00003)—irregular straw colonies.
- ○
- E. coli ATCC® 25922 (WDCM 00013)—straw colonies.
- ○
- E. coli ATCC® 8739 (WDCM 00012)—straw colonies.
- ○
- S. aureus ATCC® 25923 (WDCM 00034)—cream/straw colonies.
- Colony counts shall be equal to or greater than 70% of the control medium (Tryptone Soya Agar).
3.4.2. Escherichia coli on Chromogenic Plates
- Microbiological control of positive controls growth inoculum of 50–120 colony-forming units (cfu).
- Incubation conditions: 18–24 h @ 36 ± 2 °C, aerobic.
- Strains tested by membrane filtration.
- E. coli ATCC® 8739™ (WDCM 00012) dark blue to violet colonies.
- Enterobacter aerogenes ATCC® 13048™ (WDCM 00175) pink to red colonies.
- Colony counts shall be ≥70% of the control medium TSA.
3.4.3. Staphylococcus aureus on Reference Plates
- Inoculum of 10–100 colony-forming units (cfu).
- Incubation conditions: up to 3 days @ 30–35 °C, aerobic.
- E. coli ATCC® 8739™ 2–10 mm, cream colonies.
- S. aureus ATCC® 6538™ 1–2 mm, cream shiny colonies.
- Pseudomonas aeruginosa ATCC® 9027™ 3–8 mm, green–yellow colonies.
- Bacillus subtilis ATCC® 6633™ 3–9 mm, cream colonies.
3.4.4. Staphylococcus aureus on Chromogenic Plates
- Microbiological control of positive control growth inoculum of 50–120 colony-forming units (cfu), quantitative.
- Incubation conditions: 18–24 h @ 36 ± 1 °C, aerobic S. aureus ATCC® 33591™ 1–2 mm, blue colonies.
- Colony counts shall be ≥50% of the control medium TSA.
4. Discussion
4.1. The Discussion of the Obtained Results and Identifying Possible Mechanisms of Bacteria Growth Inhibition
4.2. Comparison of the Obtained Results with the Literature
4.3. The Novelty of the Presented Study Compared with the Literature
4.4. The Limitations of This Study and Further Research Directions
5. Conclusions
- The main components of the mineralogical composition for designed geeopolymers are quartz, 55.0%, and mullite, 42.1% of the crystalline ingredients.
- The main oxide component for the geopolymer composition is SiO2.
- The obtained results show the growth of both types of bacteria on the materials; however, after several days, the growth was inhibited.
- An assessment of microorganism growth inhibition by the cement and geopolymers shows the better efficiency of geopolymer composites in this area (in most cases).
- It should be noted that in the case of geopolymer materials, the antibacterial additive did not always fulfill its role.
- The obtained results suggest that the material does not negatively influence the bacteria, but inhibits their growth over time.
- This effect is desired in the context of potential applications of the material on water infrastructure.
Author Contributions
Funding
Institutional Review Board Statement
Informed Consent Statement
Data Availability Statement
Conflicts of Interest
Abbreviations
| EDS | energy-dispersive spectrometer |
| SEM | scanning electron microscopy |
| XRD | X-ray diffraction |
References
- Mohsen, A.; Kohail, M.; Alharbi, Y.R.; Abadel, A.A.; Soliman, A.M.; Ramadan, M. Bio-Mechanical Efficacy for Slag/Fly Ash-Based Geopolymer Mingled with Mesoporous NiO. Case Stud. Constr. Mater. 2023, 19, e02283. [Google Scholar] [CrossRef]
- Rondinella, A.; Furlani, E.; Dell’Antone, L.; Marin, E.; Boschetto, F.; Sordetti, F.; Lanzutti, A.; Andreatta, F.; Fedrizzi, L.; Maschio, S. Mechanical and Antibacterial Behavior of Multilayered Geopolymer Coatings on Ti6Al4V Alloys. J. Mater. Sci. 2022, 57, 18578–18588. [Google Scholar] [CrossRef]
- Nikolov, A.; Dobreva, L.; Danova, S.; Miteva-Staleva, J.; Krumova, E.; Rashev, V.; Vilhelmova-Ilieva, N.; Tsvetanova, L.; Barbov, B. Antimicrobial Geopolymer Paints Based on Modified Natural Zeolite. Case Stud. Constr. Mater. 2023, 19, e02642. [Google Scholar] [CrossRef]
- Luukkonen, T.; Heponiemi, A.; Runtti, H.; Pesonen, J.; Yliniemi, J.; Lassi, U. Application of Alkali-Activated Materials for Water and Wastewater Treatment: A Review. Rev. Environ. Sci. Biotechnol. 2019, 18, 271–297. [Google Scholar] [CrossRef]
- Rasaki, S.A.; Zhang, B.; Guarecuco, R.; Thomas, T.; Yang, M. Geopolymer for Use in Heavy Metals Adsorption, and Advanced Oxidative Processes: A Critical Review. J. Clean. Prod. 2019, 213, 42–58. [Google Scholar] [CrossRef]
- Růžek, V.; Novosád, J.; Buczkowska, K.E. Geopolymer Antimicrobial and Hydrophobic Modifications: A Review. Ceramics 2023, 6, 1749–1764. [Google Scholar] [CrossRef]
- Abdel-Gawwad, H.A.; Mohamed, S.A.; Mohammed, M.S. Recycling of Slag and Lead-Bearing Sludge in the Cleaner Production of Alkali Activated Cement with High Performance and Microbial Resistivity. J. Clean. Prod. 2019, 220, 568–580. [Google Scholar] [CrossRef]
- Kirthika, S.K.; Goel, G.; Matthews, A.; Goel, S. Review of the Untapped Potentials of Antimicrobial Materials in the Construction Sector. Prog. Mater. Sci. 2023, 133, 101065. [Google Scholar] [CrossRef]
- Shehab, M.S.H.; El-Gamal, S.M.A.; Hassan, H.; Mohsen, A. Recycling of Environmental Harmful Industrial Wastes in Eco-Friendly Building Materials Production Suitable for Specific Applications. J. Build. Eng. 2024, 98, 111201. [Google Scholar] [CrossRef]
- Kong, L.; Zhao, W.; Xuan, D.; Wang, X.; Liu, Y. Application Potential of Alkali-Activated Concrete for Antimicrobial Induced Corrosion: A Review. Constr. Build. Mater. 2022, 317, 126169. [Google Scholar] [CrossRef]
- Ramadan, M.; Kohail, M.; Alharbi, Y.R.; Abadel, A.A.; Binyahya, A.S.; Mohsen, A. Investigation of Autoclave Curing Impact on the Mechanical Properties, Heavy Metal Stabilization and Anti-Microbial Activity of the Green Geopolymeric Composite Based on Received/Thermally-Treated Glass Polishing Sludge. J. Mater. Res. Technol. 2023, 23, 2672–2689. [Google Scholar] [CrossRef]
- Ramadan, M.; Kohail, M.; Abadel, A.A.; Alharbi, Y.R.; Soliman, A.M.; Mohsen, A. Exploration of Mechanical Performance, Porous Structure, and Self-Cleaning Behavior for Hydrothermally Cured Sustainable Cementitious Composites Containing de-Aluminated Metakaolin Waste and TiO2 Nanoparticles. J. Mater. Res. Technol. 2023, 25, 3998–4019. [Google Scholar] [CrossRef]
- Sayed, D.G.; El-Hosiny, F.I.; El-Gamal, S.M.A.; Hazem, M.M.; Ramadan, M. Synergetic Impacts of Mesoporous α-Fe2O3 Nanoparticles on the Performance of Alkali-Activated Slag against Fire, Gamma Rays, and Some Microorganisms. J. Build. Eng. 2022, 57, 104947. [Google Scholar] [CrossRef]
- Hashimoto, S.; Machino, T.; Takeda, H.; Daiko, Y.; Honda, S.; Iwamoto, Y. Antimicrobial Activity of Geopolymers Ion-Exchanged with Copper Ions. Ceram. Int. 2015, 41, 13788–13792. [Google Scholar] [CrossRef]
- Sarkar, M.; Maiti, M.; Maiti, S.; Xu, S.; Li, Q. ZnO-SiO2 Nanohybrid Decorated Sustainable Geopolymer Retaining Anti-Biodeterioration Activity with Improved Durability. Mater. Sci. Eng. C 2018, 92, 663–672. [Google Scholar] [CrossRef]
- Sayed, D.G.; El-Gamal, S.M.A.; El-Hosiny, F.I.; Hazem, M.M.; Ramadan, M. Promoting the Performance of Green Slag-Based Geopolymer Using Eskolaite Nanoparticles for Bio-Mechanical, Thermal, and Shielding Applications. Constr. Build. Mater. 2024, 433, 136706. [Google Scholar] [CrossRef]
- Sayed, M.A.; El-Gamal, S.M.A.; Mohsen, A.; Ramadan, M.; Wetwet, M.M.; Deghiedy, N.M.; Swilem, A.E.; Hazem, M.M. Towards a Green Climate: Production of Slag–Red Brick Waste-Based Geopolymer Mingled with WO3 Nanoparticles with Bio-Mechanical Achievements. Constr. Build. Mater. 2024, 413, 134909. [Google Scholar] [CrossRef]
- Mohsen, A.; Abdel-Gawwad, H.A.; Ramadan, M. Performance, Radiation Shielding, and Anti-Fungal Activity of Alkali-Activated Slag Individually Modified with Zinc Oxide and Zinc Ferrite Nano-Particles. Constr. Build. Mater. 2020, 257, 119584. [Google Scholar] [CrossRef]
- Ahmed, D.A.; El-Apasery, M.A.; Ragai, S.M. Development of an Antimicrobial Inorganic Polymer Based on Fly Ash and Metakaolin Incorporated by Nano-TiO2 for Reactive Dye Removal. Sci. Rep. 2023, 13, 19889. [Google Scholar] [CrossRef]
- Hegyi, A.; Lăzărescu, A.-V.; Ciobanu, A.A.; Ionescu, B.A.; Grebenişan, E.; Chira, M.; Florean, C.; Vermeşan, H.; Stoian, V. Study on the Possibilities of Developing Cementitious or Geopolymer Composite Materials with Specific Performances by Exploiting the Photocatalytic Properties of TiO2 Nanoparticles. Materials 2023, 16, 3741. [Google Scholar] [CrossRef]
- Wetwet, M.M.; El-Gamal, S.M.A.; Ramadan, M.; Hazem, M.M. Multifunctional Cementitious Blends Containing Zirconia Nanoparticles: Mechanical Characteristics, Gamma Attenuation Behavior, and Self-Cleaning Performance. J. Build. Eng. 2023, 65, 105736. [Google Scholar] [CrossRef]
- Adak, D.; Sarkar, M.; Maiti, M.; Tamang, A.; Mandal, S.; Chattopadhyay, B. Anti-Microbial Efficiency of Nano Silver–Silica Modified Geopolymer Mortar for Eco-Friendly Green Construction Technology. RSC Adv. 2015, 5, 64037–64045. [Google Scholar] [CrossRef]
- Furtos, G.; Prodan, D.; Sarosi, C.; Moldovan, M.; Łach, M.; Melnychuk, M.; Korniejenko, K. Advanced Geopolymer-Based Composites for Antimicrobial Application. Materials 2023, 16, 7414. [Google Scholar] [CrossRef] [PubMed]
- Li, J.; Wang, G.; Zhu, H.; Zhang, M.; Zheng, X.; Di, Z.; Liu, X.; Wang, X. Antibacterial Activity of Large-Area Monolayer Graphene Film Manipulated by Charge Transfer. Sci. Rep. 2014, 4, 4359. [Google Scholar] [CrossRef]
- Hui, L.; Piao, J.-G.; Auletta, J.; Hu, K.; Zhu, Y.; Meyer, T.; Liu, H.; Yang, L. Availability of the Basal Planes of Graphene Oxide Determines Whether It Is Antibacterial. ACS Appl. Mater. Interfaces 2014, 6, 13183–13190. [Google Scholar] [CrossRef]
- Kumar, R.; Umar, A.; Kumar, G.; Nalwa, H.S. Antimicrobial Properties of ZnO Nanomaterials: A Review. Ceram. Int. 2017, 43, 3940–3961. [Google Scholar] [CrossRef]
- Liu, X.; Yang, Z.; Li, K.; Briseghella, B.; Marano, G.C.; Xu, J. Visible Light Antibacterial Potential of Cement Mortar Incorporating Cu-ZnO/g-C3N4 Nanocomposites. RSC Adv. 2023, 13, 9448–9456. [Google Scholar] [CrossRef]
- Xie, J.; Chu, H.; Wang, L.; Fang, Y.; Xu, Y.; Liu, D.; Jiang, L. Influences of Cu-Ti Amorphous Alloy on the Properties of Mortar: Wastewater Treatment and Bacteria Inactivation. Constr. Build. Mater. 2023, 377, 131099. [Google Scholar] [CrossRef]
- Qing, Y.; Cheng, L.; Li, R.; Liu, G.; Zhang, Y.; Tang, X.; Wang, J.; Liu, H.; Qin, Y. Potential Antibacterial Mechanism of Silver Nanoparticles and the Optimization of Orthopedic Implants by Advanced Modification Technologies. IJN 2018, 13, 3311–3327. [Google Scholar] [CrossRef]
- Gomaa, E.Z. Silver Nanoparticles as an Antimicrobial Agent: A Case Study on Staphylococcus aureus and Escherichia coli as Models for Gram-Positive and Gram-Negative Bacteria. J. Gen. Appl. Microbiol. 2017, 63, 36–43. [Google Scholar] [CrossRef]
- Růžek, V.; Dostayeva, A.M.; Walter, J.; Grab, T.; Korniejenko, K. Carbon Fiber-Reinforced Geopolymer Composites: A Review. Fibers 2023, 11, 17. [Google Scholar] [CrossRef]
- Kmiotek, A.; Figiela, B.; Łach, M.; Aruova, L.; Korniejenko, K. An Investigation of Key Mechanical and Physical Characteristics of Geopolymer Composites for Sustainable Road Infrastructure Applications. Buildings 2025, 15, 1262. [Google Scholar] [CrossRef]
- Korniejenko, K.; Łach, M.; Mikuła, J. The Influence of Short Coir, Glass and Carbon Fibers on the Properties of Composites with Geopolymer Matrix. Materials 2021, 14, 4599. [Google Scholar] [CrossRef] [PubMed]
- Drabczyk, A.; Kudłacik-Kramarczyk, S.; Korniejenko, K.; Figiela, B.; Furtos, G. Review of Geopolymer Nanocomposites: Novel Materials for Sustainable Development. Materials 2023, 16, 3478. [Google Scholar] [CrossRef]
- Łach, M.; Kozub, B.; Bednarz, S.; Bąk, A.; Melnychuk, M.; Masłoń, A. The Influence of the Addition of Basalt Powder on the Properties of Foamed Geopolymers. Materials 2024, 17, 2336. [Google Scholar] [CrossRef]
- Ziejewska, C.; Grela, A.; Mierzwiński, D.; Hebda, M. Influence of Waste Glass Addition on the Fire Resistance, Microstructure and Mechanical Properties of Geopolymer Composites. Materials 2023, 16, 6011. [Google Scholar] [CrossRef]
- Walter, J.; Uthayakumar, M.; Balamurugan, P.; Mierzwiński, D. The Variable Frequency Conductivity of Geopolymers during the Long Agieng Period. Materials 2021, 14, 5648. [Google Scholar] [CrossRef]
- Srinivas, D.; Panda, B.; Suraneni, P.; Sitharam, T.G. Influence of Mixture Composition and Carbonation Curing on Properties of Sustainable 3D Printable Mortars. J. Clean. Prod. 2025, 492, 144894. [Google Scholar] [CrossRef]
- Yoris-Nobile, A.I.; Slebi-Acevedo, C.J.; Lizasoain-Arteaga, E.; Indacoechea-Vega, I.; Blanco-Fernandez, E.; Castro-Fresno, D.; Alonso-Estebanez, A.; Alonso-Cañon, S.; Real-Gutierrez, C.; Boukhelf, F.; et al. Artificial Reefs Built by 3D Printing: Systematisation in the Design, Material Selection and Fabrication. Constr. Build. Mater. 2023, 362, 129766. [Google Scholar] [CrossRef]
- Wang, W.; Wang, S.; Peng, L.; Wang, N.; Meng, T.; Zhao, Y.; Gong, F. Preliminary Investigation and Life Cycle Assessment of Artificial Reefs with Recycled Brick-Concrete Aggregates. Constr. Build. Mater. 2024, 432, 136618. [Google Scholar] [CrossRef]
- D’Angelo, A.; Viola, V.; Fiorentino, M.; Dal Poggetto, G.; Blanco, I. Use of Natural Dyes to Color Metakaolin-Based Geopolymer Materials. Ceram. Int. 2025, 51, 5528–5535. [Google Scholar] [CrossRef]
- Viola, V.; D’Angelo, A.; Vertuccio, L.; Catauro, M. Metakaolin-Based Geopolymers Filled with Industrial Wastes: Improvement of Physicochemical Properties through Sustainable Waste Recycling. Polymers 2024, 16, 2118. [Google Scholar] [CrossRef] [PubMed]
- Růžek, V.; Svobodová, L. Comparison of Different Methods for Evaluating the Antimicrobial Activity of Geopolymer Composites Containing Metal Microparticles. In Proceedings of the 15th International Conference on Nanomaterials—Research & Application, Brno, Czech Republic, 18–20 October 2023; pp. 100–105. [Google Scholar]
- Růžek, V.; Svobodová, L.; Bakalova, T.; Ryvolová, M. Antimicrobial Activity of Geopolymers with Metal Microparticle Additive. In Proceedings of the 14th International Conference on Nanomaterials—Research & Application, Brno, Czech Republic, 19–21 October 2022; pp. 97–102. [Google Scholar]
- Hassan, H.; El-Gamal, S.M.A.; Shehab, M.S.H.; Mohsen, A. Development of Green Ternary-Blended-Geopolymers for Multifunctional Engineering Applications. Constr. Build. Mater. 2023, 409, 133869. [Google Scholar] [CrossRef]
- Kawai, T.; Kobayashi, T.; Sasaki, K.; Nishida, H.; Fujiwara, W.; Yano, S. Highly Esthetic, Deodorant, and Antibacterial Tile with Natural Zeolite Set via a Blast Furnace Slag-Based Geopolymer. J. Ceram. Soc. Jpn. 2022, 130, 100–106. [Google Scholar] [CrossRef]
- Catauro, M.; Barrino, F.; Pacifico, S.; Piccolella, S.; Lancellotti, I.; Leonelli, C. Synthesis of WEEE-Based Geopolymers and Their Cytotoxicity. Mater. Today Proc. 2021, 34, 121–124. [Google Scholar] [CrossRef]
- Dal Poggetto, G.; D’Angelo, A.; Blanco, I.; Piccolella, S.; Leonelli, C.; Catauro, M. FT-IR Study, Thermal Analysis, and Evaluation of the Antibacterial Activity of a MK-Geopolymer Mortar Using Glass Waste as Fine Aggregate. Polymers 2021, 13, 2970. [Google Scholar] [CrossRef]
- Ly, O.; Yoris-Nobile, A.I.; Sebaibi, N.; Blanco-Fernandez, E.; Boutouil, M.; Castro-Fresno, D.; Hall, A.E.; Herbert, R.J.H.; Deboucha, W.; Reis, B.; et al. Optimisation of 3D Printed Concrete for Artificial Reefs: Biofouling and Mechanical Analysis. Constr. Build. Mater. 2021, 272, 121649. [Google Scholar] [CrossRef]
- Musliha, M.G.S.; Lieding, A.M.; Ekmi, R.N.; Azlinawati, R.R.; Rashid, S.M.; Kee, L.M. Adhesion Enhancement of Poly (Acrylamide-Co-Acrylic Acid)/Polyethylene Glycol Anti-Biofouling Coating Using Fly Ash Based Geopolymer. Chem. Eng. Trans. 2020, 78, 583–588. [Google Scholar] [CrossRef]
- Subaer, S.; Fansuri, H.; Haris, A.; Misdayanti, M.; Ramadhan, I.; Wibawa, T.; Putri, Y.; Ismayanti, H.; Setiawan, A. Pervaporation Membranes for Seawater Desalination Based on Geo–rGO–TiO2 Nanocomposites: Part 2—Membranes Performances. Membranes 2022, 12, 1046. [Google Scholar] [CrossRef]

| Designation | Cement [%] | Sand [%] | Fly Ash [%] | Coal Shale from Silesia Mine [%] | Carbon Fiber [%] | Nanosilica [%] | Antibacterial Agent [%] | Solution |
|---|---|---|---|---|---|---|---|---|
| 1 | 50 | 50 | - | - | - | - | - | - |
| 2 | - | - | 79 | 20 | 1 | - | - | 10 M |
| 3 | - | - | 78.5 | 20 | 1 | 0.5 | - | 10 M |
| 4 | - | - | 78 | 20 | 1 | 0.5 | 0.5 | 10 M |
| 5 | - | - | 77.5 | 20 | 1 | 0.5 | 1 | 10 M |
| No. | Oxide | Amount [%wt.] |
|---|---|---|
| 1 | Na2O | 23.9 ± 0.2 |
| 2 | MgO | 1.4 ± 0.2 |
| 3 | Al2O3 | 16.0 ± 0.2 |
| 4 | SiO2 | 50.9 ± 0.3 |
| 5 | SO3 | 2.9 ± 0.1 |
| 6 | K2O | 2.5 ± 0.1 |
| 7 | CaO | 2.4 ± 0.1 |
| Designation | Time | Average | |||
|---|---|---|---|---|---|
| 15 min | 24 h | 48 h | 72 h | ||
| 1 | 10.6 | 12.45 | 12.40 | 12.51 | 11.99 |
| 2 | 11.30 | 12.19 | 12.27 | 12.08 | 11.96 |
| 3 | 10.62 | 11.65 | 11.90 | 12.03 | 11.55 |
| 4 | 11.42 | 12.35 | 12.40 | 12.25 | 12.11 |
| 5 | 11.66 | 12.51 | 12.53 | 12.47 | 12.29 |
| 0 | - | 9.26 | 8.76 | 9.05 | 9.02 |
| No. | Geopolymer (Composition) | Investigated Bacteria | Results | Source |
|---|---|---|---|---|
| 1 | Metakaolin activated by sodium hydroxide and sodium silicate | Escherichia coli, Pseudomonas aeruginosa, Staphylococcus aureus, Enterococcus faecalis | Antimicrobial properties against E. coli bacteria Decrease in cell viability of mitochondrial activity of fibroblast murine NIH-3T3. | [41] |
| 2 | Ground-granulated blast-furnace slag, metakaolin, fly ash, lead-bearing sludge, superplasticizer, activated by sodium hydroxide solution | Salmonella typhi, Bacillus cereus | The materials show anti-microbial activity against both tested microbial strains. | [9] |
| 3 | Metakaolin, suction dust, red mud, sludge from the food supplement industry, and sludge from partially stabilized industrial waste. Activation by sodium hydroxide and sodium silicate | Escherichia coli, Staphylococcus aureus | Confirmation of activity against bacterial strain properties for designed geopolymers, especially those that contain industrial waste. The possibility of application of geopolymer coatings against nosocomial infections. | [42] |
| 4 | Ground-granulated blast-furnace slag with nanochromia activated by sodium hydroxide solution | Escherichia coli, Staphylococcus aureus | Geopolymer composites with nanochromia inhibit the growth of microbial strains. | [16] |
| 5 | Ground-granulated blast-furnace slag, red brick waste, sodium hydroxide, superplasticizer, nanoparticles (WO3) | Salmonella typhi, Staphylococcus aureus | The antimicrobial properties of geopolymers are correlated to the presence of nanoparticles (WO3). | [17] |
| 6 | Metakaolin, microparticles (silver, copper and nickel), potassium-based activator | Escherichia coli, Micrococcus luteus | There was no clearly confirmed antibacterial activity of geopolymers without additives. The microparticles enhanced the antimicrobial activity. | [43,44] |
| 7 | Ground-granulated blast-furnace slag, fly ash, sodium hydroxide, superplasticizer, meso-porous nickel oxide nanoparticles | Salmonella typhi, Klebsiella pneumonia, Enterococcus faecalis | The slag/fly-ash-based geopolymer is a fertile environment for microorganism development. The addition of nickel oxide nanoparticles provides antibacterial properties for the material. | [1] |
| 8 | Ground-granulated blast-furnace slag, fly ash, cement kiln dust, metakaolin, superplasticizer activated by sodium hydroxide solution | Bacillus cereus, Salmonella typhi | The prepared geopolymers show antimicrobial resistance, the efficiency was dependent on the proportion of particular ingredients. | [45] |
| 9 | Fly ash, metakaolin, nano-titanium oxide, activated by sodium hydroxide and sodium silicate | Escherichia coli, Candida albicans, Pseudomonas aeruginosa | Nano-titanium oxide enhances the antimicrobial properties of geopolymers. | [19] |
| 10 | Tuff, sodium water glass, potassium hydroxide | Escherichia coli, Staphylococcus aureus | Antimicrobial tests against bacteria confirmed a wide spectrum of activity of the designed geopolymer paints. | [3] |
| 11 | Ground-granulated blast-furnace and hematite nanoparticles activated by sodium hydroxide | Escherichia coli, Staphylococcus aureus | The addition of mesoporous hematite nanoparticles to the geopolymer matrix significantly enhances antimicrobial properties. | [13] |
| 12 | Natural zeolite powder, ground-granulated blast-furnace, activated by sodium silicate solution | Escherichia coli | The geopolymers containing the zeolite had a little less antibacterial activity. | [46] |
| 13 | Metakaolin, powder glasses from waste electric and electronic equipment, activated by sodium hydroxide and sodium silicate | Escherichia coli | The research shows biocide activity of geopolymers. | [47] |
| 14 | Metakaolin, waste glass, activated by sodium hydroxide and sodium silicate | Escherichia coli, Enterococcus faecalis | Geopolymers do not have a strong impact on living organisms, showing only a slightly negative effect on E. coli and no effect on E. faecalis. | [48] |
| 15 | Ground-granulated blast-furnace slag and lead-bearing sludge activated by sodium hydroxide | Enterococcus faecalis, Bacillus subtillis, Escherichia coli | Anti-bacterial activity increases with lead-bearing sludge content. | [7] |
| 16 | Class F fly ash, zinc oxide nano-rods, silica nanoparticles, activated by sodium hydroxide and sodium silicate | Escherichia coli, Staphylococcus aureus, Aspergillus niger | The proposed composition has significant anti-microbial properties. | [15] |
| 17 | Class F fly ash, colloidal nano-silica, silver nanoparticles, activated by sodium hydroxide and sodium silicate | Escherichia coli, Staphylococcus aureus | The addition of silver–silica nanocomposite improves significantly the antibacterial properties of the geopolymer mortar. | [22] |
Disclaimer/Publisher’s Note: The statements, opinions and data contained in all publications are solely those of the individual author(s) and contributor(s) and not of MDPI and/or the editor(s). MDPI and/or the editor(s) disclaim responsibility for any injury to people or property resulting from any ideas, methods, instructions or products referred to in the content. |
© 2025 by the authors. Licensee MDPI, Basel, Switzerland. This article is an open access article distributed under the terms and conditions of the Creative Commons Attribution (CC BY) license (https://creativecommons.org/licenses/by/4.0/).
Share and Cite
Figiela, B.; Tyliszczak, B.; Bańkosz, M.; Nikolov, A.; Korniejenko, K. Studying the Impact of Cement-Based and Geopolymer Concrete on the Proliferation of Escherichia coli and Staphylococcus aureus in Water-Related Applications. Materials 2025, 18, 2560. https://doi.org/10.3390/ma18112560
Figiela B, Tyliszczak B, Bańkosz M, Nikolov A, Korniejenko K. Studying the Impact of Cement-Based and Geopolymer Concrete on the Proliferation of Escherichia coli and Staphylococcus aureus in Water-Related Applications. Materials. 2025; 18(11):2560. https://doi.org/10.3390/ma18112560
Chicago/Turabian StyleFigiela, Beata, Bożena Tyliszczak, Magdalena Bańkosz, Aleksandar Nikolov, and Kinga Korniejenko. 2025. "Studying the Impact of Cement-Based and Geopolymer Concrete on the Proliferation of Escherichia coli and Staphylococcus aureus in Water-Related Applications" Materials 18, no. 11: 2560. https://doi.org/10.3390/ma18112560
APA StyleFigiela, B., Tyliszczak, B., Bańkosz, M., Nikolov, A., & Korniejenko, K. (2025). Studying the Impact of Cement-Based and Geopolymer Concrete on the Proliferation of Escherichia coli and Staphylococcus aureus in Water-Related Applications. Materials, 18(11), 2560. https://doi.org/10.3390/ma18112560

